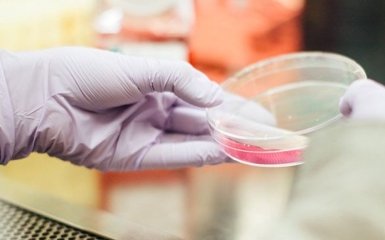
Создание искусственных микроорганизмов

Группа ученых со всего мира, среди которых лауреаты Нобелевской премии призывают научное сообщество прекратить исследования по разработке синтетических микроорганизмов.
Главные тезисы
- Создание синтетических микроорганизмов может привести к угрозе существованию жизни на планете, по мнению ведущих ученых.
- Искусственно созданные микроорганизмы могут обходить иммунную систему и вызывать неизлечимые инфекции, представляя серьезную опасность.
- Ученые рекомендуют прекратить исследования по разработке “зеркальных” микробов из-за отсутствия убедительных доказательств их безопасности.
- Потенциальная польза создания «зеркальных» молекул в фармацевтике и промышленности не оправдывает риски, связанные с обходом иммунной системы.
- Необходима открытая дискуссия на международном уровне о возможных последствиях разработки искусственных микробов для предотвращения потенциальных угроз.
Почему ведущие ученые призывают прекратить разработку синтетических микробов
Ученые в собственном отчете выражают обеспокоенность, что так называемые "зеркальные" микробы могут представлять угрозу существованию жизни на планете.
Речь идет об исследованиях, направленных на создание синтетических микроорганизмов, которые будут зеркально повторять существующие в природе.
В частности, в ДНК всех живых организмов молекулы нуклеотидов имеют "правостороннюю" структуру, а белки формируются из "левосторонних" аминокислот.

Однако ученые убеждены, что есть возможность создать искусственные микроорганизмы с противоположной структурой.
Главную опасность представляет то, что такие искусственно созданные микроорганизмы смогут обходить иммунную систему человека, животных и растений, вызывая смертельные инфекции, которые невозможно будет вылечить имеющимися средствами современной медицины.
Это беспрецедентная угроза, — предупреждает профессор из Университета Питтсбурга Вон Купер.
По его словам, такие искусственно созданные микроорганизмы будут иметь возможность бесконтрольно размножаться, поскольку без конкурентов и препятствий для этого.
При том, что создание таких зеркальных микробов может занять не одно десятилетие, уже сейчас ученые наблюдают значительные успехи в изучении зеркальных молекул.
Ряд исследователей даже проводят эксперименты с построением отдельных компонентов будущих микробов.
Это вызывает серьезную обеспокоенность у научного сообщества.
В 299-страничном отчете группа из 38 ученых призывает приостановить эти исследования.
Они также рекомендовали, чтобы финансирующие науку организации отказались поддерживать создание таких организмов.
Какую пользу может принести создание "зеркальных" молекул
Такие искусственно созданные микроорганизмы могут быть полезными в создании нового лекарства против сложных заболеваний, а также для улучшения работы промышленных производств, использующих микроорганизмы.
Пока нет убедительных доказательств, что зеркальная жизнь будет безопасной, такие исследования должны быть прекращены, — отмечают авторы отчета.
Кейт Адамала из Университета Миннесоты, ранее работавшая над созданием зеркальных клеток, после глубокого анализа рисков изменила направление своих исследований.
Она отмечает, что сейчас есть время для обсуждения, и призывает международное сообщество к открытой дискуссии.
Мы должны подумать о последствиях заранее. Это тот случай, когда нужно действовать ответственно, убеждает ученая.
Больше по теме
- Категория
- Наука и медицина
- Дата публикации
- Додати до обраного
- Категория
- Наука и медицина
- Дата публикации
- Додати до обраного
- Категория
- Наука и медицина
- Дата публикации
- Додати до обраного